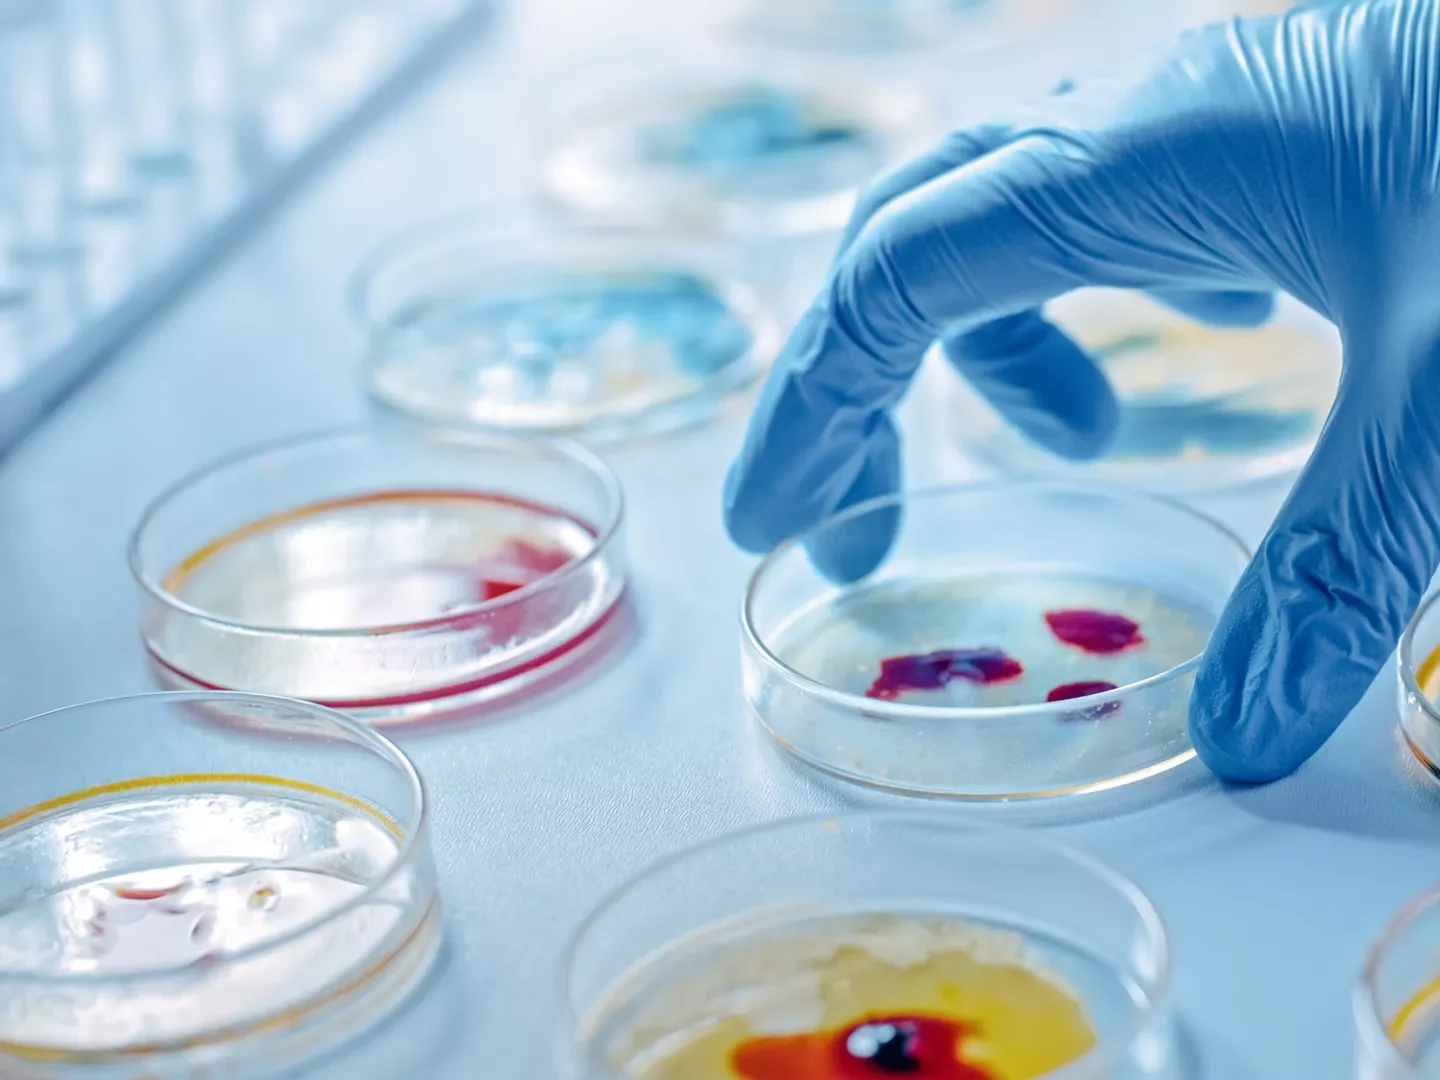

Your Health, Our Priority
Accurate Diagnostics, Trusted Care
At Sigma Diagnostics, we are guided by our vision and philosophy of offering reliable and accurate diagnostic services at affordable prices. We ensure every test result meets the highest standards of accuracy and care, with a strong customer-centric approach, especially for industrial and occupational health centers.

Excellence in diagnostics since 2010
About Sigma Diagnostics
Our lab services cover everything from routine health tests to highly specialized investigations that are not commonly available at most hospitals or laboratories. With state-of-the-art analyzers sourced from the USA, Germany, France, and Japan, combined with skilled professionals, we ensure every report meets the highest standards of quality.
At Sigma, we continuously upgrade our technology and knowledge to keep pace with global medical advancements. Our mission has always been to offer patient-friendly services with uncompromised accuracy, making us a trusted name in diagnostic healthcare.
Complete spectrum of diagnostic care under one roof
Our Services

Hematology
Comprehensive blood analysis and related diagnostics.

Clinical Pathology

Pulmonary Function Test (PFT)
Breath by Breath, Measuring Lung Health.

Histopathology & Cytopathology
Microbiology

Immunology

Digital X-Ray

Audiometry
Clear Hearing for a Better Life.
Innovation for Accurate Results
Advanced Technology
At Sigma Diagnostics, we combine world-class diagnostic equipment with automation and advanced software to deliver precise, reliable, and error-free results. Our Lab Information System ensures secure data management, instant report access, and seamless communication between patients and doctors.
Prevention is the best cure
Health Checkups
At Sigma Diagnostics, we believe periodic health check-ups are essential to monitor your health status and take timely lifestyle precautions. Our check-up packages are designed to provide a complete picture of your well-being with a focus on early detection and prevention.
- Complete Body Profile (CBP, Blood Glucose & more)
- Cardiac & Cholesterol Screening
- Diabetes & Hormonal Assays
- Cancer Marker Tests
- Infectious Disease Screening
Heart Care Check-up
Cancer Screening
Diabetes Care Check-up
Full Body Check-up
Accuracy, ethics, and patient trust
Quality Commitment

99.9% Accuracy Rate
We use advanced equipment and strict protocols to ensure every test result is highly precise and dependable.
International Quality Standards
Our processes follow globally recognized diagnostic and pathology standards for consistent excellence.
Certified Testing Processes
All our testing methods are validated and certified to meet the highest healthcare industry benchmarks.

24/7 Expert Support
Our team of qualified professionals is available around the clock to answer queries and provide guidance.

Healthier employees, stronger workforce
Corporate & Industrial Health Check-ups
From pre-employment screenings to annual check-ups and specialized occupational assessments, we provide reliable, accurate, and customized healthcare solutions for organizations. With our expertise, businesses can ensure early detection of health concerns and foster a healthier, more productive workplace.
Excellence You Can Trust
What Our Patients Say
"I’ve been visiting Sigma Diagnostics for my annual health check-up, and the accuracy of their reports is unmatched. The staff is professional, and I always receive my results on time.

